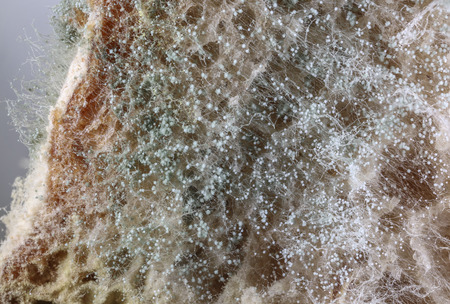
Mold on slices of bread - microscopic photoの写真素材

写真素材 - Mold on slices of bread - microscopic photo
作品情報
Mold on slices of bread - microscopic photo
- ID:64996610
- 作品種別:写真
- 作者名:Vera Kuttelvaserova Stuchelova
キーワード
- background
- bacteria
- bacterium
- bad
- baked
- biology
- black
- bread
- brown
- closeup
- decay
- detail
- dirty
- eating
- expired
- food
- fungus
- green
- horizontal
- illness
- isolated
- loaf
- macro
- micro
- microbes
- microscope
- microscopic
- microscopy
- mildew
- mold
- moldy
- mould
- mouldy
- nature
- nobody
- old
- organism
- process
- rotten
- rotting
- slice
- sliced
- spore
- toxic
- unhealthy
- unhygienic
- unsanitary
- waste
- white
類似作品
Pulp of bread m...
Toast bread sli...
three pieces of...
moldy bread tex...
Profuse mold on...
Blue sponge wit...
Mold growing ra...
White sliced br...
Texture of brow...
beautiful mold ...
Close up molded...
Bread covered w...
Slices of old m...
three pieces of...
Macro view of m...
a gloved hand h...
Sponge
Moldy slice of ...
Toast bread sli...
Fresh bread sli...
Mouldy bread is...
Whole wheat bre...
Penicillin and ...
Abstract colore...
Whole wheat bre...
Dark cocoa brea...
blue and pink m...
Top view surfac...
Moldy sliced bl...
close- up bread...
Moldy slice of ...
Profuse mold on...
Comparison of N...
three pieces of...
A close up face...
A piece of mold...
Photo of a piec...
Slice of bread ...
The bread
bread pandan le...
Crust on ruddy ...
Pulp of bread s...
Pulp of bread s...
bread as a back...
The old black m...
freshly baked r...
Sliced bread. R...
Fresh whole gra...
Moldy slice of ...